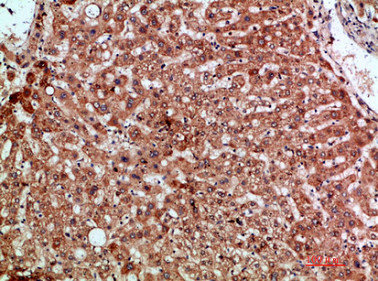

CCL20 Antibody
-
中文名稱:CCL20兔多克隆抗體
-
貨號:CSB-PA389153
-
規(guī)格:¥1090
-
圖片:
-
Immunohistochemical analysis of paraffin-embedded human-liver, antibody was diluted at 1:200
-
Immunohistochemical analysis of paraffin-embedded human-liver, antibody was diluted at 1:200
-
Immunohistochemical analysis of paraffin-embedded human-pancreas, antibody was diluted at 1:200
-
Immunohistochemical analysis of paraffin-embedded human-pancreas, antibody was diluted at 1:200
-
-
其他:
產品詳情
-
Uniprot No.:
-
基因名:
-
別名:Beta chemokine exodus 1 antibody; Beta-chemokine exodus-1 antibody; C C motif chemokine ligand 20 antibody; C-C motif chemokine 20 antibody; CC chemokine LARC antibody; Ccl20 antibody; CCL20(2-70) antibody; CCL20_HUMAN antibody; Chemokine (C C motif) ligand 20 antibody; Chemokine C-C motif chemokine 20 antibody; Chemokine CC motif ligand 20 antibody; CKb4 antibody; Exodus 1 antibody; Exodus antibody; LARC antibody; Liver and activation regulated chemokine antibody; Liver and activation-regulated chemokine antibody; Macrophage inflammatory protein 3 alpha antibody; MIP 3 alpha antibody; MIP 3A antibody; MIP-3-alpha antibody; MIP-3a antibody; MIP3 alpha antibody; MIP3A antibody; SCYA20 antibody; Small inducible cytokine A20 antibody; Small inducible cytokine subfamily A (Cys Cys) member 20 antibody; Small-inducible cytokine A20 antibody; ST38 antibody
-
宿主:Rabbit
-
反應種屬:Human,Mouse
-
免疫原:Synthetic peptide from Human protein at AA range: 31-80
-
免疫原種屬:Homo sapiens (Human)
-
標記方式:Non-conjugated
-
純化方式:The antibody was affinity-purified from rabbit serum by affinity-chromatography using specific immunogen.
-
濃度:It differs from different batches. Please contact us to confirm it.
-
保存緩沖液:Liquid in PBS containing 50% glycerol, 0.5% BSA and 0.02% sodium azide.
-
產品提供形式:Liquid
-
應用范圍:IHC,ELISA
-
推薦稀釋比:
Application Recommended Dilution IHC IHC-p:1:50-300 ELISA 1:10000-20000 -
Protocols:
-
儲存條件:Upon receipt, store at -20°C or -80°C. Avoid repeated freeze.
-
貨期:Basically, we can dispatch the products out in 1-3 working days after receiving your orders. Delivery time maybe differs from different purchasing way or location, please kindly consult your local distributors for specific delivery time.
-
用途:For Research Use Only. Not for use in diagnostic or therapeutic procedures.
相關產品
靶點詳情
-
功能:Acts as a ligand for C-C chemokine receptor CCR6. Signals through binding and activation of CCR6 and induces a strong chemotactic response and mobilization of intracellular calcium ions. The ligand-receptor pair CCL20-CCR6 is responsible for the chemotaxis of dendritic cells (DC), effector/memory T-cells and B-cells and plays an important role at skin and mucosal surfaces under homeostatic and inflammatory conditions, as well as in pathology, including cancer and various autoimmune diseases. CCL20 acts as a chemotactic factor that attracts lymphocytes and, slightly, neutrophils, but not monocytes. Involved in the recruitment of both the proinflammatory IL17 producing helper T-cells (Th17) and the regulatory T-cells (Treg) to sites of inflammation. Required for optimal migration of thymic natural regulatory T cells (nTregs) and DN1 early thymocyte progenitor cells. C-terminal processed forms have been shown to be equally chemotactically active for leukocytes. Positively regulates sperm motility and chemotaxis via its binding to CCR6 which triggers Ca2+ mobilization in the sperm which is important for its motility. Inhibits proliferation of myeloid progenitors in colony formation assays. May be involved in formation and function of the mucosal lymphoid tissues by attracting lymphocytes and dendritic cells towards epithelial cells. Possesses antibacterial activity towards E.coli ATCC 25922 and S.aureus ATCC 29213.
-
基因功能參考文獻:
- CCN1 stimulates CCL20 production in vitro and in vivo, and thus supports the notion that overexpressed CCN1 in hyperproliferating keratinocyte is functionally involved in the recruitment of inflammatory cells to skin lesions affected by psoriasis. PMID: 28602508
- Results demonstrated that F. nucleatum ssp. animalis and dysregulated CCL20 protein expression are important factors associated with human colorectal cancer progression. PMID: 28483840
- There was underexpression of the majority of genes after sunitinib treatment. The lower expression levels of IGFBP1, CCL20, CXCL6 and FGB were confirmed by qRT-PCR in all cases. The downregulation of gene expression leads us to search for methylation as a mechanism of action of the tyrosine kinase inhibitors PMID: 27834463
- CCL20 contributed to invasion and epithelial-mesenchymal transition of RANK over-expressed endometrial cancer cells PMID: 27015366
- High expression of CCL20 is associated with cutaneous T-cell lymphoma. PMID: 26789110
- These results showed that the higher levels of CXCL10, CCL20 and CCL22 were associated with ischemic heart disease. The serum levels of chemokines may influence by the certain traditional risk factors of IHD and some studied SNPs, but did not influence by treatment and gender of patients. PMID: 27152707
- The strongest OR was for CXCL8 (interleukin-8) in serum (96.8, 95% CI: 11.9-790.2). Of these 15 markers, 6 were also significantly elevated in serum from Chile (CCL20, C-reactive protein, CXCL8, CXCL10, resistin, serum amyloid A). PMID: 27173614
- CCR6(-) regulatory T cells blunt the restoration of gut Th17 cells along the CCR6-CCL20 axis in treated HIV-1-infected patients. PMID: 26883727
- CCL20 provoked a 2.5-fold increase of cell migration and invasion in human cancerous breast epithelial cells ; CCL20 also enhanced MMP- 2 and MMP-9 mRNAs/protein expression and activities. PMID: 28618084
- A gut-specific endogenously produced mediator with the capacity to modulate the IL-17/Th17 signaling response. PMID: 28526351
- results provide a potential explanation for involvement of the CCL20-CCR6 system in the trafficking of IL-17-producing cells to degenerated IVD tissues PMID: 23823618
- MFSD2B, CCL20 and STAT1, or STARD7 and ZNF512 genes may be risk or protect factors in prognosis of ADC; HTR2B, DPP4, and TGFBRAP1 genes may be risk factors in prognosis of SQC. PMID: 27301951
- HMC stimulated by IgA1 could produce CCL20 and consequently recruit inflammatory Th17 cells to the kidneys to induce further lesion in IgA nephropathy PMID: 28552941
- High CCL20 expression is associated with B-lymphoblastic lymphoma with inflammation. PMID: 27018255
- primary cultures of human bronchial epithelial cells and the BEAS-2B cell line were used to examine the effects of bacterial-viral coexposure, as well as each stimulus alone, on epithelial expression of CXCL8 and, in particular, CCL20. PMID: 28283475
- Study provides evidence that tumor cells signal to the surrounding healthy cells through CCL20 inducing the modulation of the expression of molecules involved in EMT and promoting angiogenesis directly and indirectly through the secretion of VEGF, a major contributor to angiogenesis. PMID: 26154142
- CCL20-recruited immune cells further increase TRAIL resistance of CCL20-producing pancreatic ductal adenocarcinoma cells. PMID: 28188806
- Cytomegalovirus replication in the allograft causes an intrapulmonary increase of CCL-18 and CCL-20 and a systemic rise of CCL-20 serum levels. PMID: 26910332
- This study evaluated the role of CCL20 and CCR6 in the regulation of laryngeal neoplasms; it showed that these proteins acted on proliferation and metastasis via the p38 pathway and multiple microRNAs. PMID: 27916417
- findings provide insight into the important role of macrophage-secreted CCL20 in pancreatic cancer and implicate CCR6/CCL20 as potential therapeutic targets PMID: 27797715
- Production of CCL20 from lung cancer cells induces the cell migration and proliferation through PI3K pathway. PMID: 26968871
- There were early increased plasma concentrations of CCL20 and CCR6 in patients with sepsis. CCL20 and CCR6 correlate with severity of illness in ICU patients. PMID: 26771764
- ADAM10 activity contributes to house dust mite-induced shedding of chemokines, including CCL20 PMID: 26296735
- Both MIP-3alpha and cystatin A overexpressions in NPC tumor tissues were strong independent factors of poor prognosis in NPC patients. PMID: 26634210
- High-risk HPV-type lesions might inhibit the chemokine CCL20 on Langerhans cells through E6 and E7 to escape the immune response. PMID: 26400278
- High CCL20 expression is associated with Inflammatory Bowel Disease. PMID: 26536229
- Tregs of unexplained recurrent miscarriage patients was significantly lower than that in controls. CCL20-CCR6 could drive immune activity of CD4(+)FOXP3(+) Tregs, followed by their migration to the feto-maternal microenvironment PMID: 26345847
- human lung epithelial cells secrete CCL20 and BD2 in response to B. abortus and/or to cytokines produced by infected monocytes. PMID: 26448160
- AEG-1 mediates CCL20/CCR6-induced EMT development via both Erk1/2 and Akt signaling pathway in cervical cancer, which indicates that CCL20/CCR6-AEG-1-EMT pathway could be suggested as a useful target to affect the progression of cervical cancer. PMID: 26156805
- CCL20 enhanced osteoblast-mediated osteoclastogenesis, partly via IL-6 production, suggesting that CCL20 may contribute to osteoporosis in rheumatoid arthritis by affecting bone cell communication. PMID: 26103626
- Th17 cells are recruited into tumor tissues preferentially through CCR6-CCL20 pathway PMID: 25768730
- High CCL20 expression is associated with colon cancer. PMID: 24866282
- stimulates leukocyte migration in ovary, may aid in final ovulatory events PMID: 26125463
- CCL20 cooperated with CCR6 could recruit T regulatory cells to tumor sites, and chemotherapy medicine docetaxel could decrease the expression of CCL20. PMID: 25661365
- CCL20 expression is associated with HCC recurrence and patient survival and promotes HCC cell proliferation and migration by inducing EMT-like changes via PI3K/AKT and Wnt/beta-catenin pathways. PMID: 25593462
- A TGF-beta-responsive enhancer element required for efficient IL-1beta-dependent expression of the proinflammatory chemokine CCL20 by human lung fibroblasts. PMID: 25918170
- Results indicate that CCL20 is crucial for tobacco smoke-caused lung cancer, and anti-CCL20 could be a rational approach to fight against this deadly disease. PMID: 25864589
- Overexpression of CCL20 in human proximal tubular cells is inhibited by blockade of KCa3.1 under diabetic conditions through inhibition of the NF-kappaB pathway. PMID: 24733189
- glucocorticoids enhance CCL20 production by bronchial epithelium, which may constitute a novel mechanism in Th17-mediated glucocorticoid-insensitive inflammation in asthma PMID: 24627531
- We conclude that CCL 20 mRNA expression in the conjunctival epithelium plays a crucial role in regulating homeostasis at the ocular surface and in exacerbation of vernal keratoconjunctivitis . PMID: 25172034
- CCL20 rs6749704 polymorphism was associated with secondary progressive multiple sclerosis. PMID: 24395091
- identify Syk as an upstream signaling molecule in IL-17A-induced Act1-TRAF6 interaction in keratinocytes, and inhibition of Syk can attenuate CCL20 production PMID: 25202827
- CCL20 could be an immune marker in ANCA-associated vasculitis. PMID: 25352172
- a differential regulation pattern for genes solely expressed in Th17 cells (IL17A and CCL20) compared to genes expressed in both Th17 and Th1 cells (IL23R and IL12RB2), where high levels of promoter methylation are correlated to near zero PMID: 22715389
- CCL20 levels were significantly elevated in the CSF of patients with pneumococcal meningitis. PMID: 24699535
- CCL20 and 14-3-3 zeta are molecules that play a putative role during tumorgenesis in pancreas, and may therefore be new parameters for histological diagnosis and discrimination between pancreatic neoplasms and chronic pancreatitis. PMID: 24629487
- CCR6/CCL20 biological axis increased the capacity of proliferation and adhesion, as well as the chemotactic migration and the level of cytokines related to degraded extracellular matrix. PMID: 24743888
- Data indicate that periodontal ligament stem cells (hPDLSCs) express a functional P2X7 ATP receptor, whose activation is linked to the production of pro-inflammatory molecules IL8 and CCL20. PMID: 24851271
- genetic and biological role of the C-C chemokine ligand CCL20 and the C-C chemokine receptor CCR6in rheumatoid arthritis, is discussed.[review] PMID: 24394994
- IL-6 produced from IL-1beta-stimulated human periodontal ligament cells could increase CCL20 production. PMID: 24081898
顯示更多
收起更多
-
亞細胞定位:Secreted.
-
蛋白家族:Intercrine beta (chemokine CC) family
-
組織特異性:Expressed in the seminal plasma, endometrial fluid and follicular fluid (at protein level). Expressed predominantly in the liver, lymph nodes, appendix, peripheral blood lymphocytes, and fetal lung. Low levels seen in thymus, prostate, testis, small intes
-
數(shù)據(jù)庫鏈接:
Most popular with customers
-
-
YWHAB Recombinant Monoclonal Antibody
Applications: ELISA, WB, IHC, IF, FC
Species Reactivity: Human, Mouse, Rat
-
Phospho-YAP1 (S127) Recombinant Monoclonal Antibody
Applications: ELISA, WB, IHC
Species Reactivity: Human
-
-
-
-
-